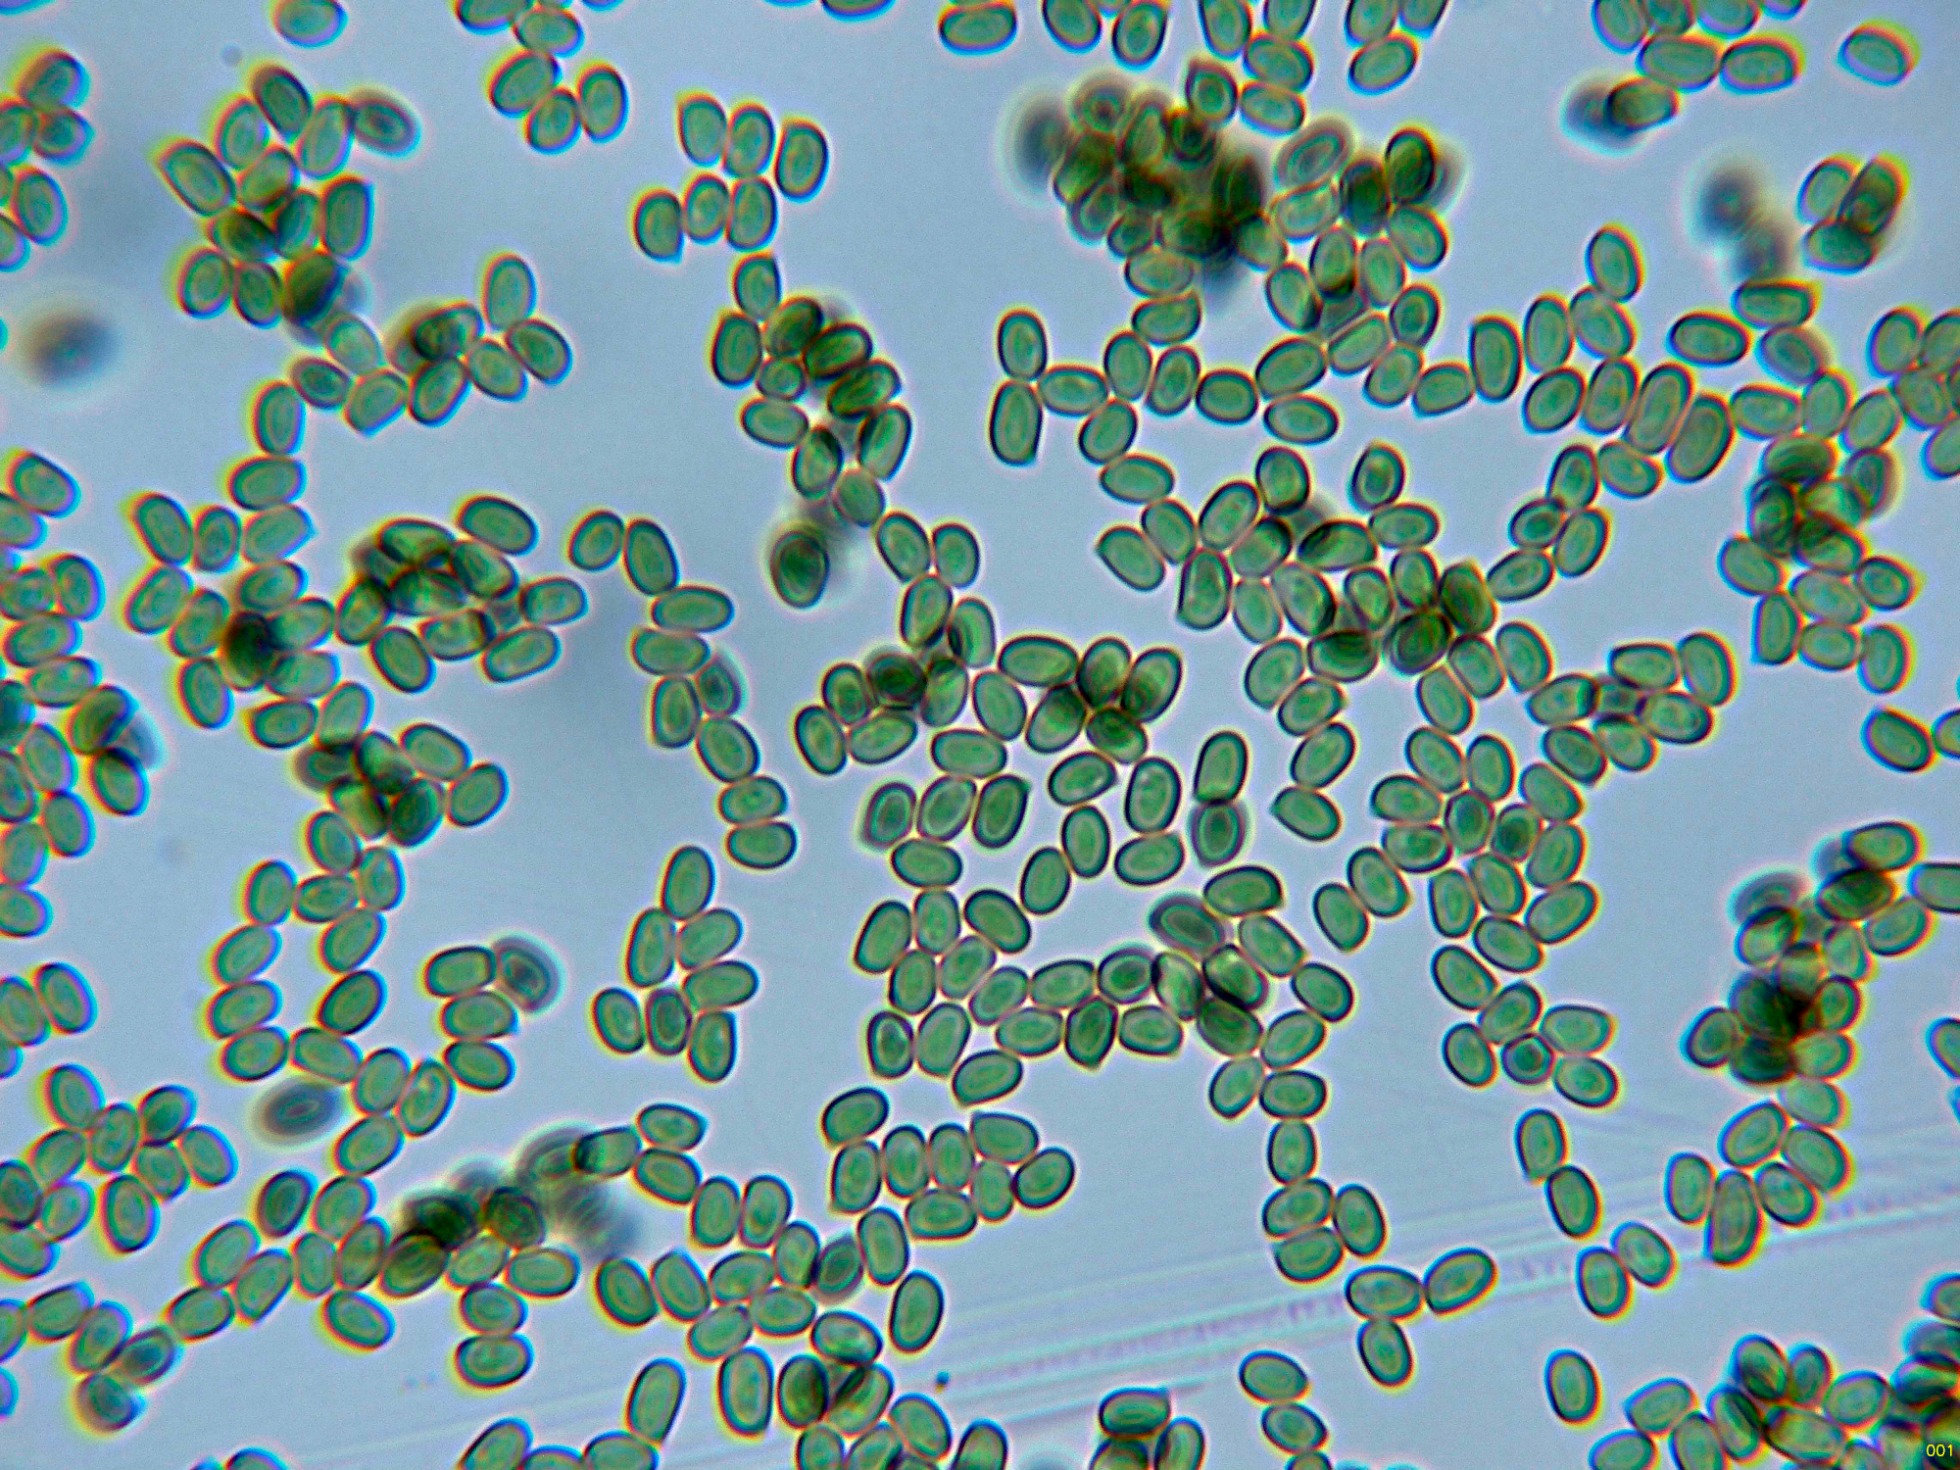
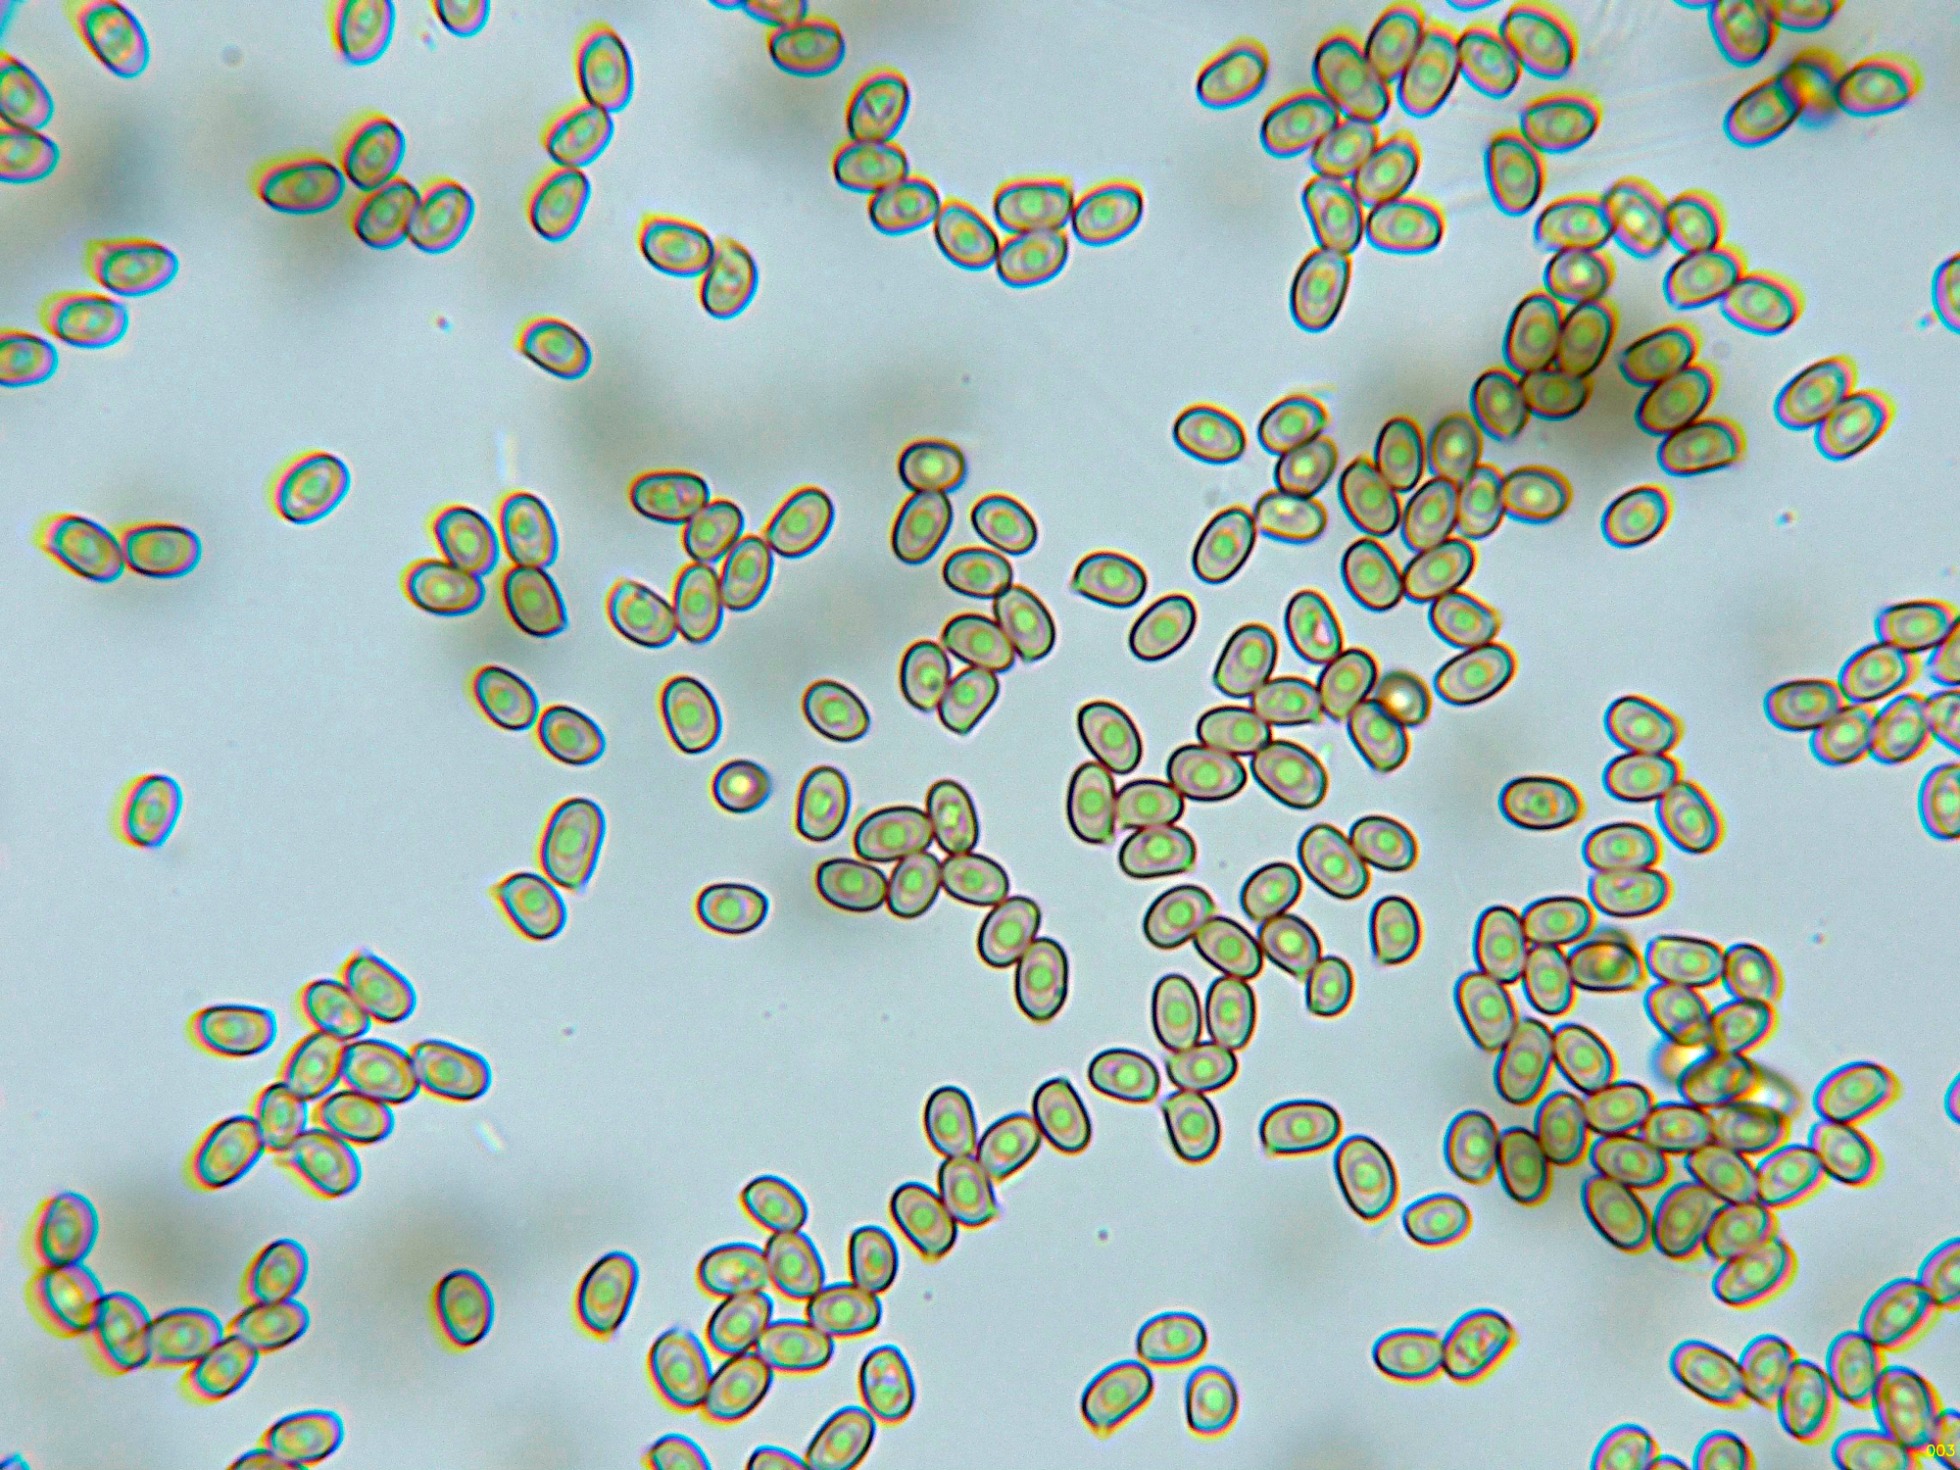
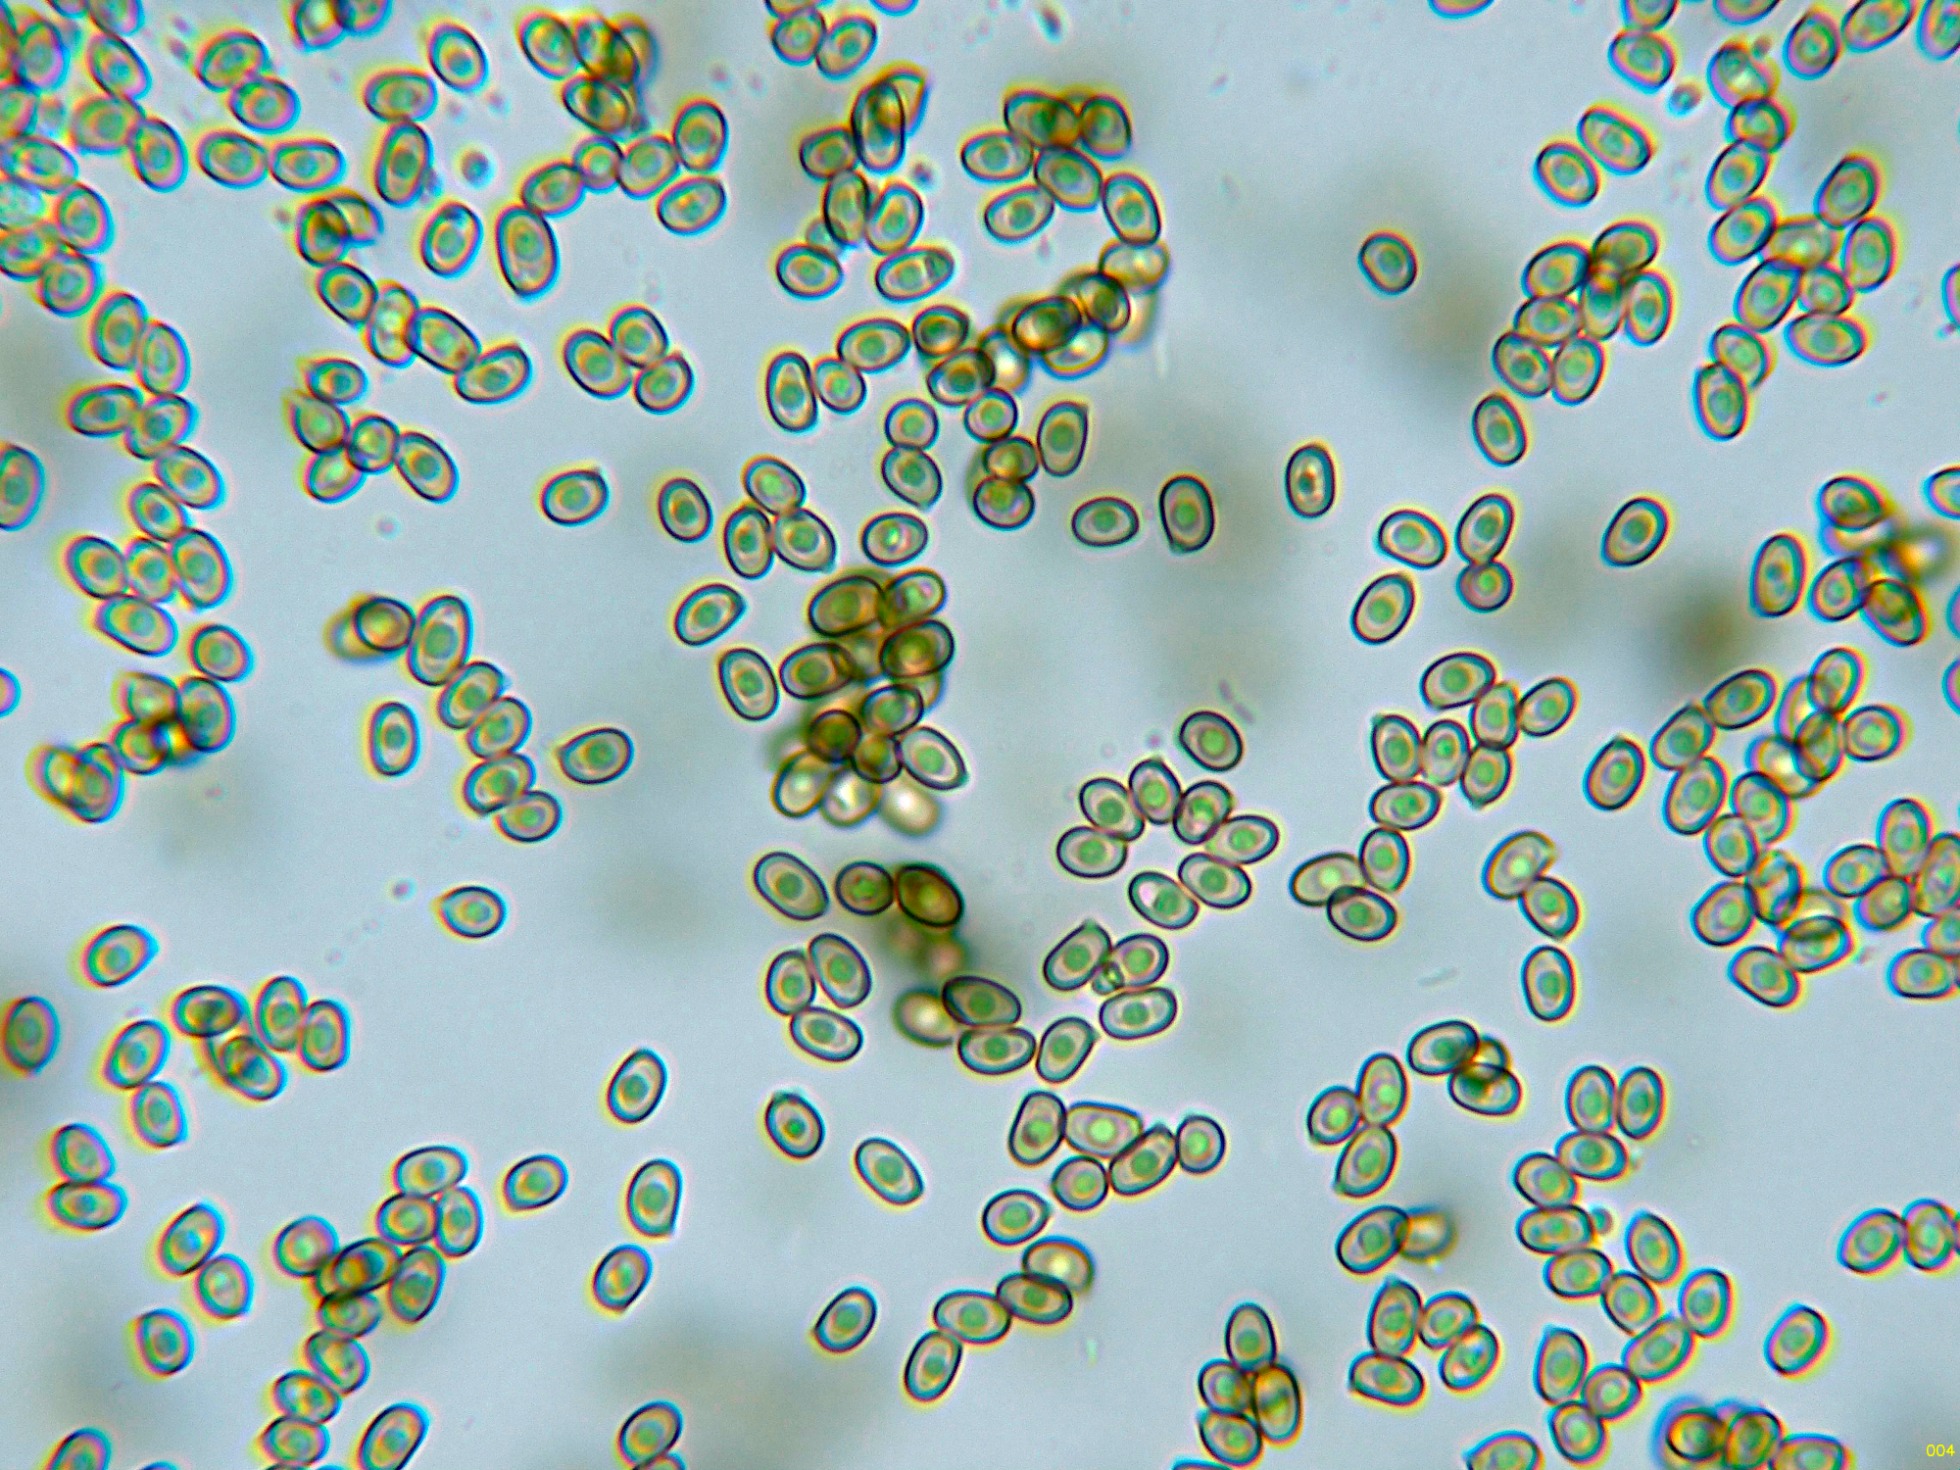
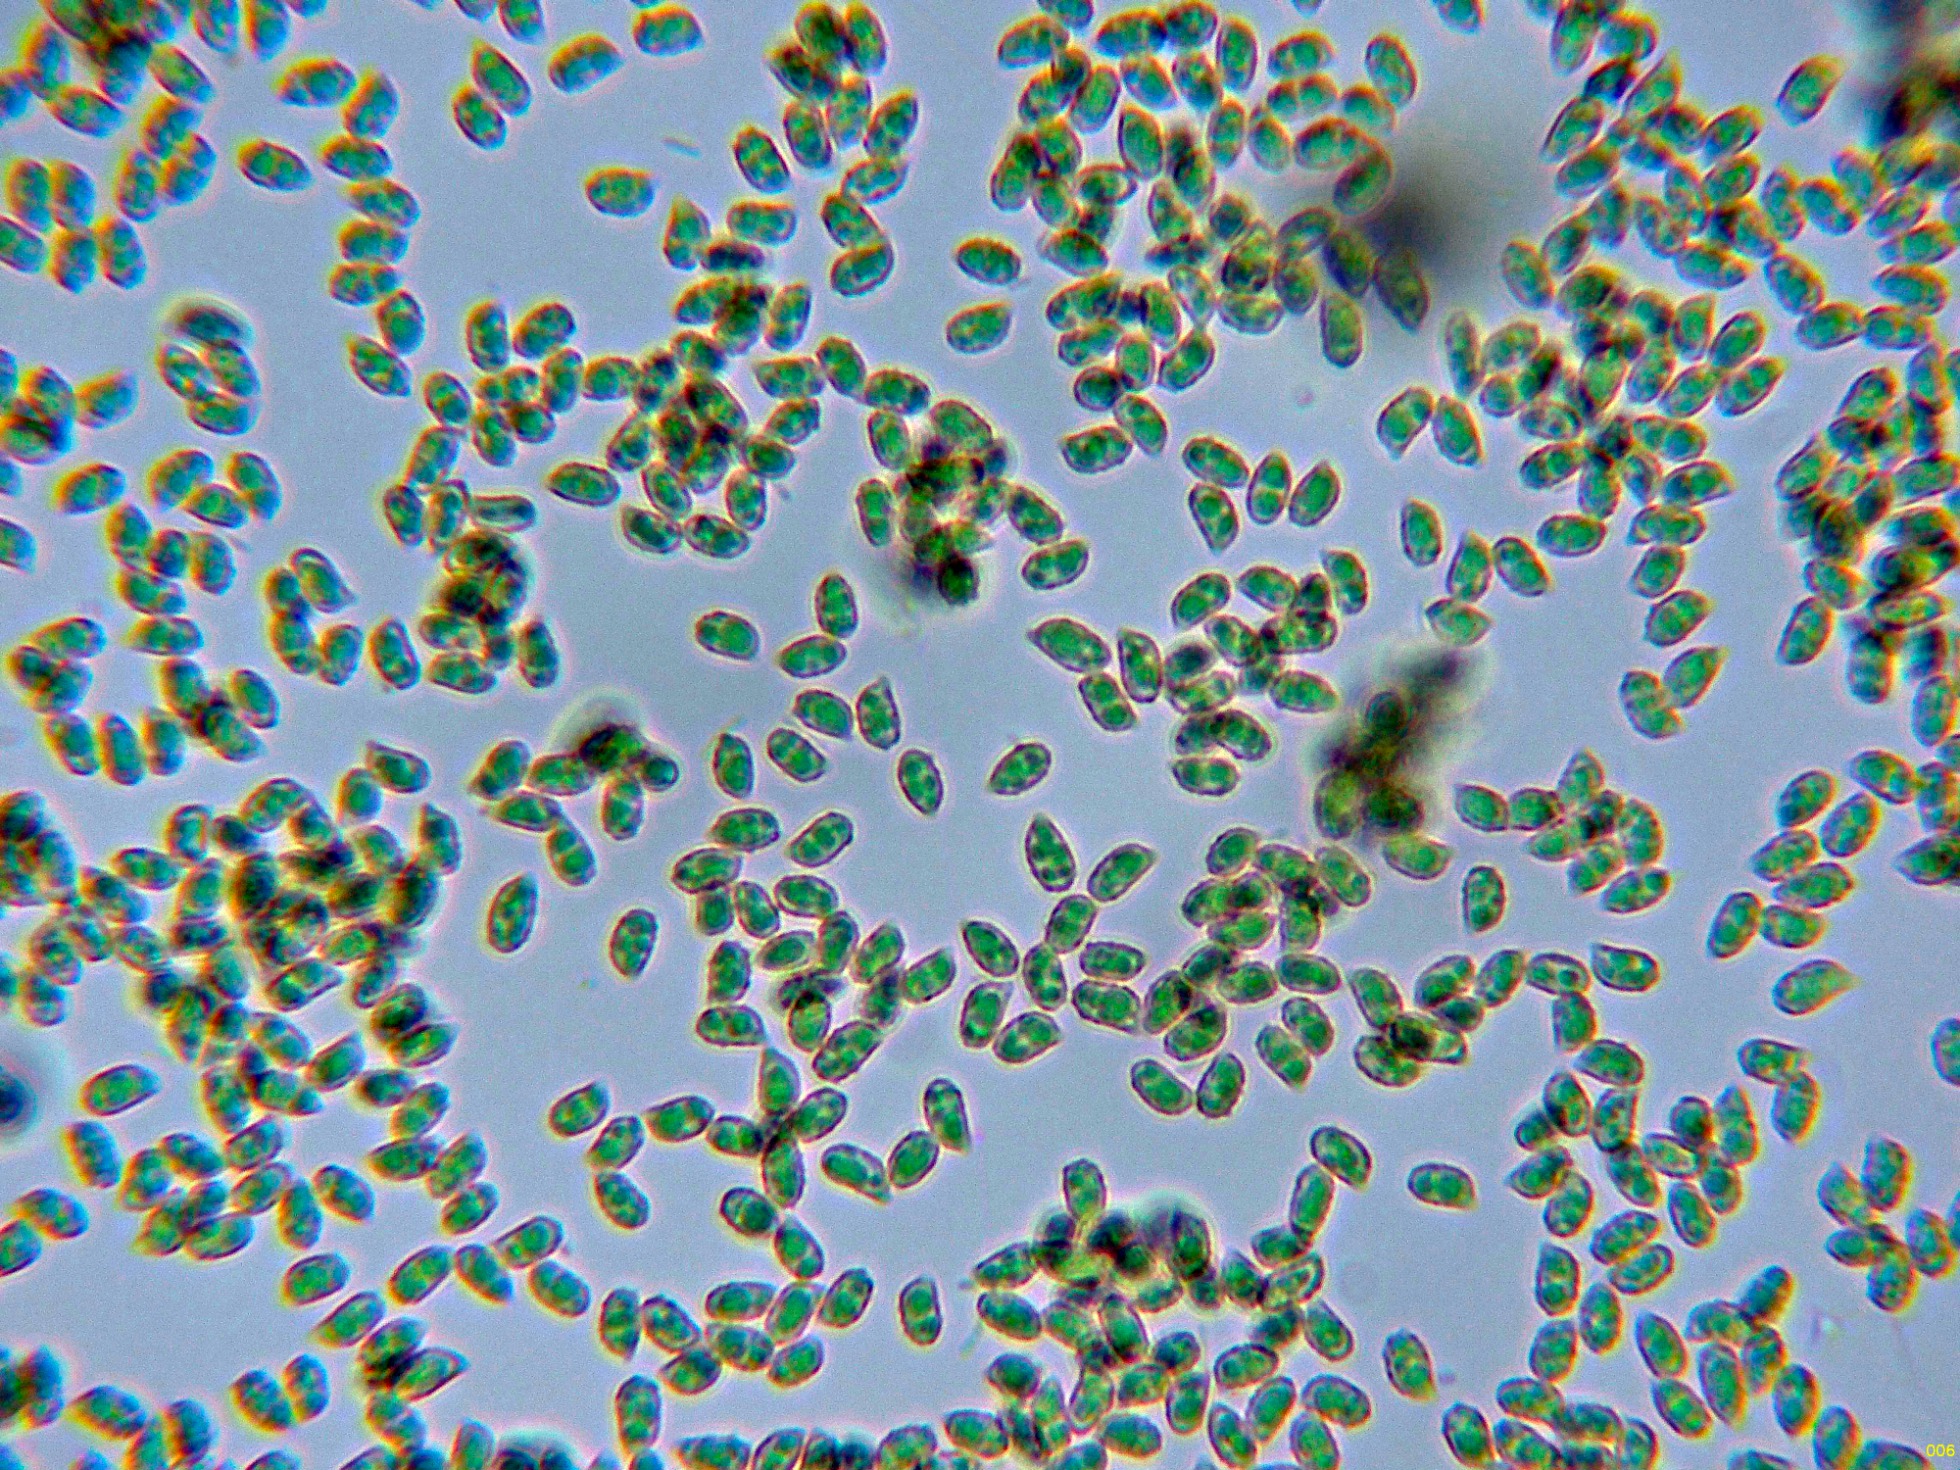

- Foro
- Foros sobre Micología de fungipedia
- Microscopía
- En agradecimiento a los Fungimasters: Una parte del resto.
 En agradecimiento a los Fungimasters: Una parte del resto.
En agradecimiento a los Fungimasters: Una parte del resto.
- Josep Torres
-
 Autor del tema
Autor del tema
- Fuera de línea
- Moderador
-

Menos
Más
- Mensajes: 8746
- Gracias recibidas: 8379
2 años 3 meses antes - 2 años 3 meses antes #109678
por Josep Torres
Hola a tod@s.
Una docena de hongos, que recibí de los Fungimasters.
El primero un par de Agaricus de unos 3,5 cm. el mayor.
Carne muy enrojeciente al corte.
Hifas de la suprapellis en agua, con pigmento intracelular marrón.
Arista laminar sin cistidios diferenciados, con basidios tetraspóricos.
Las esporas en KOH.
Las esporas en agua.
Estas esporas obtenidas por esporulación natural y en agua con unas medidas de:
(4.6) 4.9 - 5.6 (5.7) × (3.2) 3.3 - 3.7 (3.8) µm
Q = (1.4) 1.41 - 1.7 (1.8) ; N = 40
Me = 5.3 × 3.4 µm ; Qe = 1.5
A pesar de su pequeño tamaño, que induce a pensar en un Agaricus de la sección minores, atendiendo a las escamas de color pardo del sombrero, la carne muy enrojeciente al corte y las esporas todas por debajo de las 6 micras de largo, todo indica que estamos ante el abundante Agaricus sylvaticus.
Un hongo de aspecto Crepitoide.
Una imágen a 20 aumentos.
Arista laminar homomorfa, sin elementos diferenciados.
Los basidios y en la miniatura superior las esporas.
Esta con la microscopía resulta muy fácil de identificar, por la ausencia de cistidios y sobre todo por las esporas estriadas, no puede tratarse de ninguna que no sea el Clitopilus hobsonii.
Un Geastrum sin cuello diferenciado, con el peristoma fimbriado.
Hifas del capilicio no ramificadas, de gruesas paredes y sin septos.
Las esporas en agua.
Estas esporas en agua con unas medidas de:
(3) 3.1 - 3.4 (3.5) × (2.9) 2.94 - 3.3 (3.4) µm
Q = 1 - 1.06 (1.1) ; N = 30
Me = 3.3 × 3.2 µm ; Qe = 1
Todas sus características apuntan al muy abundante Geastrum fimbriatum.
Un Hygrocybe con un bello color anaranjado.
Hifas de la suprapellis en agua.
Los basidios de la cara laminar.
Y las esporas enagua.
Estas esporas con unas medidas de (7.6) 7.9 - 12.3 (12.9) × (6.3) 6.5 - 8.6 (9.3) µm con un cociente Q de (1.1) 1.2 - 1.4 (1.5) ; y una medida de Qe = 1.3.
Siguiendo las claves de Funga Nordica, me conducen a la Hygrocybe acutoconica var konradii, para muchos sinonimizada con la Hygrocybe acutoconica, punto que no comprendo ya tan solo por sus basidios tetraspóricos (bisporicos en el caso de la Hygrocybe acutoconica) y por el cociente Q esporal de Q = 1.5-2.5, en el caso de la Hygrocybe acutoconica.
Esta prefiero guardarla en mis archivos como Hygrocybe konradii.o ya como la define P.D. Orton, como Hygrocybe subglobispora.
Un Clitocybe como diría Javi, un poco raruno.
Hifas de la suprapellis, pigmentadas y fibuladas.
La arista laminar sin cistidios diferenciados.
Los basidios de la cara laminar.
Las esporas obtenidas por esporulación natural y en agua.
En la miniatura superior las esporas en Reactivo de Melzer (inamiloides).
Estas esporas en agua con unas medidas de:
(5.9) 6.5 - 7.9 (9.1) × (3.5) 3.8 - 4.4 (4.9) µm
Q = 1.6 - 1.9 (2.1) ; N = 40
Me = 7.3 × 4.1 µm ; Qe = 1.8
La microscopía entra bien dentro del rango de lo que se podría considerar como Clitocybe gibba, actualmente Infundibulicybe gibba.
Un Inocybe.
Un par de ejemplares, con el sombrero escamosillo.
Ampliación de la superficie del sombrero a 20 aumentos.
Hifas de la suprapellis filamentosas, con pigmento intracelular de color marrón y provistas de fíbulas.
Caulocistidios de la parte alta del pie.
Sin aparentemente caulocistidios en la parte media del pie, aunque si que pude observar alguna hifa terminal redondeada que se podría corresponder con algún caulocistidio ya muy disperso.
Queilocistidios de dos tipos.
Pleurocistidios abundantes con una morfología parecida a los queilocistidios.
Las esporas en agua.
Estas esporas con unas medidas de (8.1) 8.2 - 10 (11.2) × (4.4) 4.5 - 5.2 (5.5) µm.
Atendiendo a todos los datos obtenidos y utilizando las claves de "Les Champignons de Suisse", conducen a la más que abundante Inocybe flocculosa sl., y ya más concretamente a la var. flocculosa.
Seguimos..............................................
Una docena de hongos, que recibí de los Fungimasters.
El primero un par de Agaricus de unos 3,5 cm. el mayor.
Carne muy enrojeciente al corte.
Hifas de la suprapellis en agua, con pigmento intracelular marrón.
Arista laminar sin cistidios diferenciados, con basidios tetraspóricos.
Las esporas en KOH.
Las esporas en agua.
Estas esporas obtenidas por esporulación natural y en agua con unas medidas de:
(4.6) 4.9 - 5.6 (5.7) × (3.2) 3.3 - 3.7 (3.8) µm
Q = (1.4) 1.41 - 1.7 (1.8) ; N = 40
Me = 5.3 × 3.4 µm ; Qe = 1.5
A pesar de su pequeño tamaño, que induce a pensar en un Agaricus de la sección minores, atendiendo a las escamas de color pardo del sombrero, la carne muy enrojeciente al corte y las esporas todas por debajo de las 6 micras de largo, todo indica que estamos ante el abundante Agaricus sylvaticus.
Un hongo de aspecto Crepitoide.
Una imágen a 20 aumentos.
Arista laminar homomorfa, sin elementos diferenciados.
Los basidios y en la miniatura superior las esporas.
Esta con la microscopía resulta muy fácil de identificar, por la ausencia de cistidios y sobre todo por las esporas estriadas, no puede tratarse de ninguna que no sea el Clitopilus hobsonii.
Un Geastrum sin cuello diferenciado, con el peristoma fimbriado.
Hifas del capilicio no ramificadas, de gruesas paredes y sin septos.
Las esporas en agua.
Estas esporas en agua con unas medidas de:
(3) 3.1 - 3.4 (3.5) × (2.9) 2.94 - 3.3 (3.4) µm
Q = 1 - 1.06 (1.1) ; N = 30
Me = 3.3 × 3.2 µm ; Qe = 1
Todas sus características apuntan al muy abundante Geastrum fimbriatum.
Un Hygrocybe con un bello color anaranjado.
Hifas de la suprapellis en agua.
Los basidios de la cara laminar.
Y las esporas enagua.
Estas esporas con unas medidas de (7.6) 7.9 - 12.3 (12.9) × (6.3) 6.5 - 8.6 (9.3) µm con un cociente Q de (1.1) 1.2 - 1.4 (1.5) ; y una medida de Qe = 1.3.
Siguiendo las claves de Funga Nordica, me conducen a la Hygrocybe acutoconica var konradii, para muchos sinonimizada con la Hygrocybe acutoconica, punto que no comprendo ya tan solo por sus basidios tetraspóricos (bisporicos en el caso de la Hygrocybe acutoconica) y por el cociente Q esporal de Q = 1.5-2.5, en el caso de la Hygrocybe acutoconica.
Esta prefiero guardarla en mis archivos como Hygrocybe konradii.o ya como la define P.D. Orton, como Hygrocybe subglobispora.
Un Clitocybe como diría Javi, un poco raruno.
Hifas de la suprapellis, pigmentadas y fibuladas.
La arista laminar sin cistidios diferenciados.
Los basidios de la cara laminar.
Las esporas obtenidas por esporulación natural y en agua.
En la miniatura superior las esporas en Reactivo de Melzer (inamiloides).
Estas esporas en agua con unas medidas de:
(5.9) 6.5 - 7.9 (9.1) × (3.5) 3.8 - 4.4 (4.9) µm
Q = 1.6 - 1.9 (2.1) ; N = 40
Me = 7.3 × 4.1 µm ; Qe = 1.8
La microscopía entra bien dentro del rango de lo que se podría considerar como Clitocybe gibba, actualmente Infundibulicybe gibba.
Un Inocybe.
Un par de ejemplares, con el sombrero escamosillo.
Ampliación de la superficie del sombrero a 20 aumentos.
Hifas de la suprapellis filamentosas, con pigmento intracelular de color marrón y provistas de fíbulas.
Caulocistidios de la parte alta del pie.
Sin aparentemente caulocistidios en la parte media del pie, aunque si que pude observar alguna hifa terminal redondeada que se podría corresponder con algún caulocistidio ya muy disperso.
Queilocistidios de dos tipos.
Pleurocistidios abundantes con una morfología parecida a los queilocistidios.
Las esporas en agua.
Estas esporas con unas medidas de (8.1) 8.2 - 10 (11.2) × (4.4) 4.5 - 5.2 (5.5) µm.
Atendiendo a todos los datos obtenidos y utilizando las claves de "Les Champignons de Suisse", conducen a la más que abundante Inocybe flocculosa sl., y ya más concretamente a la var. flocculosa.
Seguimos..............................................
Adjuntos:
Última Edición: 2 años 3 meses antes por Josep Torres. Razón: Una falta de ortografía
Por favor, Identificarse para unirse a la conversación.
- Josep Torres
-
 Autor del tema
Autor del tema
- Fuera de línea
- Moderador
-

Menos
Más
- Mensajes: 8746
- Gracias recibidas: 8379
2 años 3 meses antes #109679
por Josep Torres
Respuesta de Josep Torres sobre el tema En agradecimiento a los Fungimasters: Una parte del resto.
Otro Inocybe, en este caso con el sombrero liso y de color blanquecino.
Hifas de la suprapellis, lisas, hialinas, sin incrustaciones, algunas de ellas ramificadas y con fíbulas.
Caulocistidios presentes solo en la parte alta del pie.
Los queilocistidios.
Pleurocistidios abundantes de una morfología muy parecida a los queilocistidios.
Sus basidios tetrasporicos.
Las esporas en agua.
Estas esporas obtenidas por esporulación natural y en agua con unas medidas de:
(7.4) 7.9 - 9.3 (9.5) × (4.1) 4.4 - 5.3 (5.4) µm
Q = (1.6) 1.63 - 2 ; N = 40
Me = 8.7 × 4.8 µm ; Qe = 1.8
A pesar de que los Inocybes acostumbran a ser bastante complicados, no parece ser este el caso, ya que todo encaja perfectamente con la Inocybe geophila tipo.
Un Ascomiceto, que en un primer momento se encontraba aún inmaduro y la microscopía no aportó nada, solo después de mantenerlo unos días en incubadora ya empezó a dar frutos.
La superficie externa a 20 aumentos.
El excípulo medular en Reactivo de Melzer.
La materia interascal a modo de paráfisis en Melzer.
Los ascos en agua.
Y las esporas obtenidas por esporulación natural y en agua.
Estas esporas con unas medidas de:
(20) 20.3 - 23.3 (24.3) × (5) 5.2 - 6 (6.2) µm
Q = (3.5) 3.6 - 4.4 (4.7) ; N = 24
Me = 21.7 × 5.5 µm ; Qe = 3.9
Esta a pesar de su aspecto, con la microscopía la reconocí al instante, se trata sin ninguna duda de un primordio de Leotia lubrica.
Una Ramaria con tonos verdosos.
Superficie de su carne al aplicar KOH, oscureciendo a un color marrón verdoso.
Los basidios.
Las esporas en azul de Cresilo.
Las esporas en agua.
Estas esporas en agua con unas medidas de:
(6.6) 6.8 - 8.4 (9.1) × (3) 3.3 - 4 (4.6) µm
Q = (1.7) 1.8 - 2.5 (2.9) ; N = 30
Me = 7.5 × 3.7 µm ; Qe = 2
En este caso admito que ni tan siquiera era necesaria la microscopía, su aspecto ya la delataba, se trata de la Ramaria abietina, actualmente Phaeoclavulina abietina.
Vamos con otra Ramaria.
Las hifas tramales.
Sus basidios tetraspóricos.
Las esporas en azul de Cresilo.
Las esporas en agua.
Estas pequeñas esporas obtenidas por esporulación natural con unas medidas de:
(4.3) 4.6 - 5.5 (5.8) × (2.5) 2.7 - 3.1 (3.2) µm
Q = (1.5) 1.6 - 1.9 (2) ; N = 30
Me = 5 × 2.9 µm ; Qe = 1.7
Atendiendo a su aspecto y sus pequeñas medidas esporales, no puedo pensar en ninguna otra que no sea la Ramaria curta, actualmente denominada Phaeoclavulina curta.
Seguimos...............................
Hifas de la suprapellis, lisas, hialinas, sin incrustaciones, algunas de ellas ramificadas y con fíbulas.
Caulocistidios presentes solo en la parte alta del pie.
Los queilocistidios.
Pleurocistidios abundantes de una morfología muy parecida a los queilocistidios.
Sus basidios tetrasporicos.
Las esporas en agua.
Estas esporas obtenidas por esporulación natural y en agua con unas medidas de:
(7.4) 7.9 - 9.3 (9.5) × (4.1) 4.4 - 5.3 (5.4) µm
Q = (1.6) 1.63 - 2 ; N = 40
Me = 8.7 × 4.8 µm ; Qe = 1.8
A pesar de que los Inocybes acostumbran a ser bastante complicados, no parece ser este el caso, ya que todo encaja perfectamente con la Inocybe geophila tipo.
Un Ascomiceto, que en un primer momento se encontraba aún inmaduro y la microscopía no aportó nada, solo después de mantenerlo unos días en incubadora ya empezó a dar frutos.
La superficie externa a 20 aumentos.
El excípulo medular en Reactivo de Melzer.
La materia interascal a modo de paráfisis en Melzer.
Los ascos en agua.
Y las esporas obtenidas por esporulación natural y en agua.
Estas esporas con unas medidas de:
(20) 20.3 - 23.3 (24.3) × (5) 5.2 - 6 (6.2) µm
Q = (3.5) 3.6 - 4.4 (4.7) ; N = 24
Me = 21.7 × 5.5 µm ; Qe = 3.9
Esta a pesar de su aspecto, con la microscopía la reconocí al instante, se trata sin ninguna duda de un primordio de Leotia lubrica.
Una Ramaria con tonos verdosos.
Superficie de su carne al aplicar KOH, oscureciendo a un color marrón verdoso.
Los basidios.
Las esporas en azul de Cresilo.
Las esporas en agua.
Estas esporas en agua con unas medidas de:
(6.6) 6.8 - 8.4 (9.1) × (3) 3.3 - 4 (4.6) µm
Q = (1.7) 1.8 - 2.5 (2.9) ; N = 30
Me = 7.5 × 3.7 µm ; Qe = 2
En este caso admito que ni tan siquiera era necesaria la microscopía, su aspecto ya la delataba, se trata de la Ramaria abietina, actualmente Phaeoclavulina abietina.
Vamos con otra Ramaria.
Las hifas tramales.
Sus basidios tetraspóricos.
Las esporas en azul de Cresilo.
Las esporas en agua.
Estas pequeñas esporas obtenidas por esporulación natural con unas medidas de:
(4.3) 4.6 - 5.5 (5.8) × (2.5) 2.7 - 3.1 (3.2) µm
Q = (1.5) 1.6 - 1.9 (2) ; N = 30
Me = 5 × 2.9 µm ; Qe = 1.7
Atendiendo a su aspecto y sus pequeñas medidas esporales, no puedo pensar en ninguna otra que no sea la Ramaria curta, actualmente denominada Phaeoclavulina curta.
Seguimos...............................
Adjuntos:
El siguiente usuario dijo gracias: Juan
Por favor, Identificarse para unirse a la conversación.
- Josep Torres
-
 Autor del tema
Autor del tema
- Fuera de línea
- Moderador
-

Menos
Más
- Mensajes: 8746
- Gracias recibidas: 8379
2 años 3 meses antes - 2 años 3 meses antes #109680
por Josep Torres
Respuesta de Josep Torres sobre el tema En agradecimiento a los Fungimasters: Una parte del resto.
Un hongo con aspecto de Clitocybe y que acostumbro a encontrar todos los años a finales de otoño o ya a principios de invierno.
Hifas de la suprapellis filamentosas, dispuestas mas o menos de forma paralela e incrustadas de pigmento marrón.
Las hifas de la suprapellis en agua.
Arista laminar sin elementos diferenciados de los basidios o basidiolos.
.
Basidios de la cara laminar.
Las esporas en Reactivo de Melzer, con un color grisáceo (ligeramente amiloides).
Las esporas obtenidas por esporulación natural y en agua.
Estas esporas en agua con unas medidas de:
(7.8) 8.1 - 9 (9.5) × (5.1) 5.7 - 6.4 (6.7) µm
Q = (1.3) 1.35 - 1.5 (1.7) ; N = 32
Me = 8.4 × 6 µm ; Qe = 1.4
Con algunas dudas, atendiendo a su aspecto así como a la morfología y medidas esporales, aunque la anchura esporal se encuentra ligeramente por encima de la que se indica en la bibliografía de que dispongo, ya solo por la presencia de fíbulas en ela pileipellis, parece que estamos ante la Clitocybe sinopica, actualmente Bonomyces sinopicus.
Con medidas esporales muy parecidas tenemos a la Clitocybe lateritia, actualmente Infundibulicybe lateritia, esta última con un sombrero ya muy oscuro y esporas con un tamaño ligeramente mayor.
Y por último un ascomiceto que deduzco lo añadió Juan Andrés.
Un Belén de los 4 ejemplares recibidos.
Solo tuve que observar la superficie de su pie a 40 aumentos.
Este ya lo estudié a fondo 5 años atrás y fue gracias precisamente porque Juan Andrés me lo mandó, dejo el anlece:
www.fungipedia.org/setas-informacion-y-c...n-andres.html#101784
Ya tan solo saqué imágenes de sus esporas.
Las esporas obtenidas por esporulación natural, en agua y a 400 aumentos.
En este nuevo estudio, sus esporas con unas medidas de:
(101.4) 125.4 - 152.5 (158.4) × (3.8) 4.6 - 5.9 (6.6) µm
Q = (19.7) 21.9 - 30.6 (40.5) ; N = 24
Me = 139.3 × 5.3 µm ; Qe = 26.9
Saludos a tod@s.
Hifas de la suprapellis filamentosas, dispuestas mas o menos de forma paralela e incrustadas de pigmento marrón.
Las hifas de la suprapellis en agua.
Arista laminar sin elementos diferenciados de los basidios o basidiolos.
.
Basidios de la cara laminar.
Las esporas en Reactivo de Melzer, con un color grisáceo (ligeramente amiloides).
Las esporas obtenidas por esporulación natural y en agua.
Estas esporas en agua con unas medidas de:
(7.8) 8.1 - 9 (9.5) × (5.1) 5.7 - 6.4 (6.7) µm
Q = (1.3) 1.35 - 1.5 (1.7) ; N = 32
Me = 8.4 × 6 µm ; Qe = 1.4
Con algunas dudas, atendiendo a su aspecto así como a la morfología y medidas esporales, aunque la anchura esporal se encuentra ligeramente por encima de la que se indica en la bibliografía de que dispongo, ya solo por la presencia de fíbulas en ela pileipellis, parece que estamos ante la Clitocybe sinopica, actualmente Bonomyces sinopicus.
Con medidas esporales muy parecidas tenemos a la Clitocybe lateritia, actualmente Infundibulicybe lateritia, esta última con un sombrero ya muy oscuro y esporas con un tamaño ligeramente mayor.
Y por último un ascomiceto que deduzco lo añadió Juan Andrés.
Un Belén de los 4 ejemplares recibidos.
Solo tuve que observar la superficie de su pie a 40 aumentos.
Este ya lo estudié a fondo 5 años atrás y fue gracias precisamente porque Juan Andrés me lo mandó, dejo el anlece:
www.fungipedia.org/setas-informacion-y-c...n-andres.html#101784
Ya tan solo saqué imágenes de sus esporas.
Las esporas obtenidas por esporulación natural, en agua y a 400 aumentos.
En este nuevo estudio, sus esporas con unas medidas de:
(101.4) 125.4 - 152.5 (158.4) × (3.8) 4.6 - 5.9 (6.6) µm
Q = (19.7) 21.9 - 30.6 (40.5) ; N = 24
Me = 139.3 × 5.3 µm ; Qe = 26.9
Saludos a tod@s.
Adjuntos:
Última Edición: 2 años 3 meses antes por Josep Torres. Razón: Cambiar el nombre de una especie
El siguiente usuario dijo gracias: Juan Andrés Román, Juan
Por favor, Identificarse para unirse a la conversación.
- Javi Calvo
-

- Fuera de línea
- Spammer
-

Menos
Más
- Mensajes: 7009
- Gracias recibidas: 2955
2 años 3 meses antes #109683
por Javi Calvo
Respuesta de Javi Calvo sobre el tema En agradecimiento a los Fungimasters: Una parte del resto.
Hola Josep, pues me ha servido de gran ayuda estas identificaciones, El Clitopilus hobsonii, estaba convencido de que era ese, lo había visto otros años por la zona, pero por una cosa u otra no lo habiamos pasado por el micro, ahora ya está confirmado. Otra duda era el Hygrocybe, no termino de aclararme con esos en el espectro de acutoconica, estoy muy de acuerdo contigo en que dadas sus diferencias no se puede sinonimizar con acutoconica, mi duda era entre konradii y persistens, no se como estará ahora el tema. La Phaeoclavulina abietina como bien dices estaba cantada, sin embargo la curta no la tenemos hecha, otro cromo para hacer que tenemos. El Trichoglossum es muy común por esta zona, había cientos, de las llamadas "lenguas de tierra", es la que más abunda, aunque salen muchas otras. El que me genera muchas dudas es el Pseudoclitocybe cyathiformis, veo miles de ellos y nunca vi uno con ese aspecto, me ha descuadrado mucho al ver la micro, pero es que no se me ocurre que otra cosa podría ser.....quizás haya más especies dentro de ese género próximas. Un saludo artista....
El siguiente usuario dijo gracias: Josep Torres, Juan
Por favor, Identificarse para unirse a la conversación.
- Josep Torres
-
 Autor del tema
Autor del tema
- Fuera de línea
- Moderador
-

Menos
Más
- Mensajes: 8746
- Gracias recibidas: 8379
2 años 3 meses antes - 2 años 3 meses antes #109686
por Josep Torres
Respuesta de Josep Torres sobre el tema En agradecimiento a los Fungimasters: Una parte del resto.
Gracias Javi.
Fíjate que en mi tema ya pongo lo de "con algunas dudas" en el caso del Pseudoclitocybe, aunque la microscopía en general encaja muy bien con la especie, sucede que en alguna de las imágenes de la pileipellis, me pareció ver alguna fíbula dispersa, y el Pseudoclitocybe cyathiformis, todas las veces anteriores que lo he estudiado, no presentaba fíbulas, de ahí las dudas.
Saludos
Fíjate que en mi tema ya pongo lo de "con algunas dudas" en el caso del Pseudoclitocybe, aunque la microscopía en general encaja muy bien con la especie, sucede que en alguna de las imágenes de la pileipellis, me pareció ver alguna fíbula dispersa, y el Pseudoclitocybe cyathiformis, todas las veces anteriores que lo he estudiado, no presentaba fíbulas, de ahí las dudas.
Saludos
Última Edición: 2 años 3 meses antes por Josep Torres.
El siguiente usuario dijo gracias: Juan Andrés Román, Juan
Por favor, Identificarse para unirse a la conversación.
- Josep Torres
-
 Autor del tema
Autor del tema
- Fuera de línea
- Moderador
-

Menos
Más
- Mensajes: 8746
- Gracias recibidas: 8379
2 años 3 meses antes - 2 años 3 meses antes #109688
por Josep Torres
Respuesta de Josep Torres sobre el tema En agradecimiento a los Fungimasters: Una parte del resto.
Hola Javi.
Creo que ya tan solo la presencia de fíbulas en la pileipellis debemos descartar la Pseudoclitocybe, la presencia o no de fíbulas es un dato que no debemos tomarlo a broma, así que esta mañana he reabierto el tema, y con láminas decurrentes, semejantes medidas esporales y con fíbulas, tenemos la Clitocybe sinopica, actualmente Bonomyces sinopicus, este sería un cromo que tenía pendiente , así que ya he editado el tema.
Añado una imágen de la pileipellis donde he marcado con un círculo donde me ha parecido ver estas fíbulas.
Saludos cordiales.
Creo que ya tan solo la presencia de fíbulas en la pileipellis debemos descartar la Pseudoclitocybe, la presencia o no de fíbulas es un dato que no debemos tomarlo a broma, así que esta mañana he reabierto el tema, y con láminas decurrentes, semejantes medidas esporales y con fíbulas, tenemos la Clitocybe sinopica, actualmente Bonomyces sinopicus, este sería un cromo que tenía pendiente , así que ya he editado el tema.
Añado una imágen de la pileipellis donde he marcado con un círculo donde me ha parecido ver estas fíbulas.
Saludos cordiales.
Adjuntos:
Última Edición: 2 años 3 meses antes por Josep Torres.
El siguiente usuario dijo gracias: Juan Andrés Román, Juan
Por favor, Identificarse para unirse a la conversación.
- Foro
- Foros sobre Micología de fungipedia
- Microscopía
- En agradecimiento a los Fungimasters: Una parte del resto.
Tiempo de carga de la página: 0.793 segundos

Foro de micología